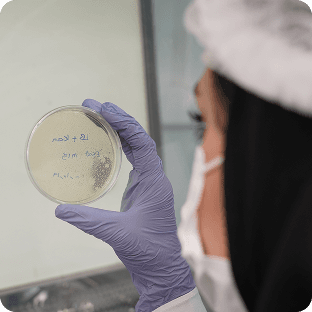
Courses, Regulatory

Innovation
Where science becomes solutions
We lead advanced biotech solutions that reshape industries and improve lives.
Engineering the Future of Life Sciences
We bring innovation to life with high-impact biotech and pharma solutions through end-to-end engineering, intelligent infrastructure, and scientific expertise. From concept to commissioning, we support every phase: process development, facility design, regulatory compliance, and operational excellence.
We support you at every step — from concept to completion.

You bring the idea. We bring the insight. Together, we define your vision, align on goals, assess feasibility, and shape an initial concept that sets the foundation.

We drive product upgrades, capacity optimization, automation, and validation — ensuring your operations stay future-ready.
Engineering Services

We deliver turnkey biotech and pharmaceutical sites — designed to global standards, built for performance.
EPC – Design & Build

From strain development and CGT to full CDMO services, we power the biotech value chain with precision and care.
Biotech Solutions
Stay compliant and informed with our expert-led training programs, regulatory consulting, and documentation solutions — empowering teams with knowledge and confidence.
Courses, Regulatory